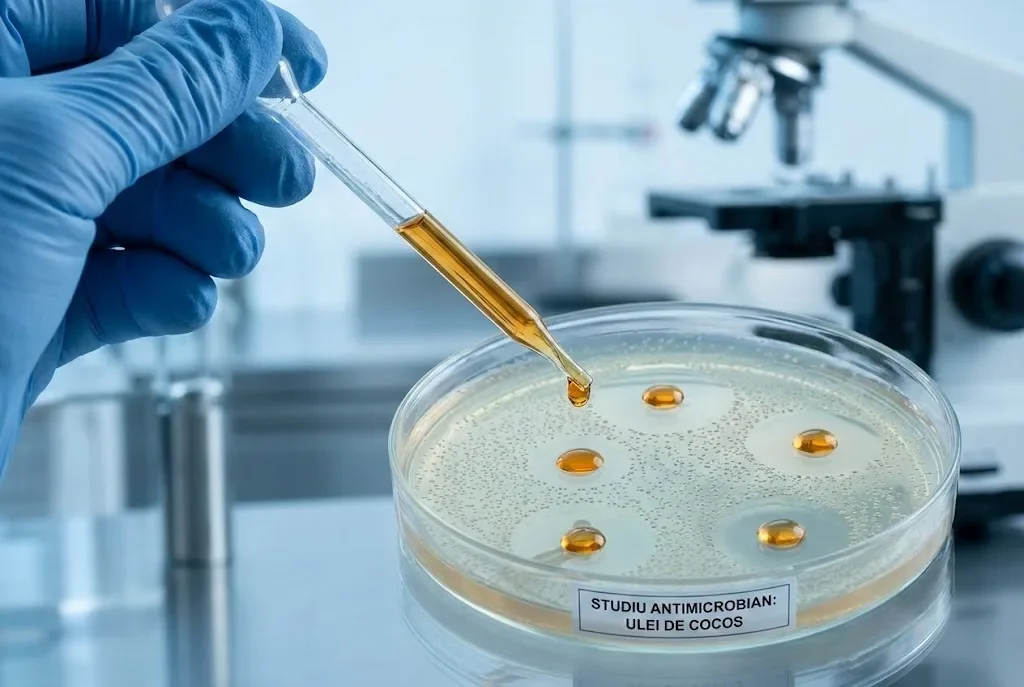
Nuca de cocos: beneficii dovedite pentru sanatate

Știi că nuca de cocos poate fi mai mult decât o simplă gustare exotică? Cercetările recente arată că acest fruct tropical conține acizi grași cu lanț mediu care metabolizează diferit față de alte grăsimi. Un studiu clinic din 2020 publicat în Journal of Cardiovascular Diseases confirmă că acizii grași din nuca de cocos cresc colesterolul HDL (cel bun) fără a afecta negativ raportul lipidic.
Aproape 90% din grăsimile nucii de cocos sunt saturate. Pare contradictoriu cu sfaturile nutriționiștilor tradiționale, nu? Realitatea este mai nuanțată. MCT-urile (trigliceride cu lanț mediu) din cocos funcționează diferit la nivel metabolic.
În acest articol descoperi compoziția nutritivă exactă, beneficiile validate științific și cum să integrezi nuca de cocos în alimentația ta zilnică.
Cuprins
Ce este nuca de cocos și de unde provine
Nuca de cocos (Cocos nucifera) este miezul fructului palmierului de cocos, nu o nucă în sens botanic. Palmierul crește până la 30 metri înălțime pe coastele tropicale din Asia de Sud-Est, Oceanul Pacific și America Centrală.
Fructul constă din trei straturi. Stratul exterior fibros (exocarp) protejează coaja dură (endocarp). Interior găsești pulpa albă (endosperm) și lichidul transparent numit apă de cocos.
Numele provine din cuvântul portughez “coco” care înseamnă “cap de maimuță”. Exploratorii portughezi din secolul XV au observat că cele trei pete de pe nucă seamănă cu ochii și gura unei maimuțe.
Cumpara din magazin:
O nucă matură cântărește între 1,5 și 2,5 kg. Comercial, principalii producători sunt Indonezia, Filipine și India care asigură peste 70% din producția globală. De aici se exportă zilnic tone de produse derivate către piețe internaționale.
Compoziție nutritivă și valoare calorică
100 de grame de pulpă crudă de nuca de cocos conțin 354 de calorii. Este un aliment caloric dens din cauza concentrației mari de grăsimi. Dar nu orice tip de grăsimi.
| Nutrient | Cantitate per 100g | % VZR* |
|---|---|---|
| Calorii | 354 kcal | 18% |
| Proteine | 3,3 g | 7% |
| Grăsimi totale | 33,5 g | 43% |
| — din care saturate | 29,7 g | 149% |
| — din care mononesaturate | 1,4 g | — |
| Carbohidrați | 15,2 g | 6% |
| Fibre | 9 g | 36% |
| Zahăruri naturale | 6,2 g | — |
| Potasiu | 356 mg | 10% |
| Magneziu | 32 mg | 8% |
| Fier | 2,4 mg | 13% |
| Zinc | 1,1 mg | 10% |
| Cupru | 0,43 mg | 48% |
| Mangan | 1,5 mg | 65% |
| Seleniu | 10,1 mcg | 18% |
Acidul lauric (C12) reprezintă 47% din grăsimile nucii de cocos, urmat de acidul mirisctic (18%) și acidul palmitic (9%). Cercetările arată că acidul lauric are proprietăți antimicrobiene puternice împotriva bacteriilor gram-pozitive precum Staphylococcus aureus. Acest lucru explică de ce uleiul de cocos se folosește atât în cosmetică cât și în suplimente.
Apa de cocos diferă complet ca profil nutritiv. Conține doar 19 calorii per 100ml, fără grăsimi, dar bogată în electroliți. Potasiul ajunge la 250mg/100ml, de patru ori mai mult decât băuturile sportive comerciale.
Beneficii dovedite științific pentru sănătate

1. Îmbunătățește profilul lipidic și sănătatea cardiovasculară
Un studiu randomizat din 2016 pe 116 participanți arată că consumul zilnic de ulei de cocos virgin crește HDL-colesterolul cu până la 15% în 8 săptămâni. HDL-ul elimină colesterolul din artere și îl transportă la ficat pentru eliminare. Procesul reduce riscul de plăci ateromatoase.
Cumpara din magazin:
Acizii grași cu lanț mediu (MCT) din nuca de cocos se metabolizează diferit. Ficatul îi transformă direct în cetone, fără a trece prin sistemul limfatic ca grăsimile cu lanț lung. Acest proces reduce formarea de depozite adipoase.
Cercetările confirmă că MCT-urile din cocos nu cresc riscul cardiovascular la persoane sănătoase. Chiar dacă grăsimile saturate din cocos nu afectează inima la fel ca cele din carne roșie, consumul exagerat poate crește totuși LDL-colesterolul la persoanele sensibile.
2. Susține hidratarea și echilibrul electrolitic
Apa de cocos conține cinci electroliți esențiali. Un studiu din 2012 publicat în Journal of the International Society of Sports Nutrition compară apa de cocos cu băuturile sportive. Rezultatele arată performanță similară în rehidratare după efort fizic intens. Simplu și direct.
Potasiul ajută la contracția musculară normală. Magneziul reglează transmiterea impulsurilor nervoase. Sodiul menține volumul sanguin și tensiunea arterială.
În timpul celui de-Al Doilea Război Mondial, medicii din Pacific au folosit apa de cocos sterilă ca substitut de urgență pentru plasma sangvină. Compoziția sa de electroliți se apropie de cea a sângelui uman, făcând-o compatibilă pentru perfuzie intravenoasă în situații extreme.
3. Ajută la controlul glicemiei și managementul diabetului
Fibrele din nuca de cocos încetinesc absorbția glucozei în sânge. 100g de pulpă conține 9g fibre, reprezentând 36% din necesarul zilnic. Această cantitate reduce spikeurile glicemice după mese. Cercetările recente din 2024 confirmă că apa de cocos îmbunătățește nivelul zahărului după masă.
Indicele glicemic al nucii de cocos este doar 45, clasificând-o ca aliment cu IG scăzut. Pentru persoanele cu diabet tip 2, alimentele cu IG sub 55 sunt potrivite pentru stabilizarea glicemiei pe termen lung.
4. Proprietăți antimicrobiene și antivirale
Acidul lauric se transformă în monolaurină în organism, un compus cu efect letal asupra membranelor lipidice ale bacteriilor și virușilor. Studii de laborator confirmă că monolaurina inhibă creșterea Clostridium difficile, o bacterie responsabilă de infecții intestinale severe.
Cercetările arată eficacitate împotriva mai multor agenți patogeni. Staphylococcus aureus (inclusiv tulpini MRSA rezistente) prezintă rată de inhibare de 90% în studiile in vitro. Escherichia coli reduce cu 80% coloniile bacteriene după expunere la acidul lauric.
- Candida albicans — fungus responsabil de infecții cu drojdie, sensibil la monolaurină în concentrații minime, cu efect similar antifungicelor comerciale dar fără efecte secundare sistemice
- Herpes simplex virus (HSV) — monolaurina dezintegrează învelișul viral, prevenind replicarea și reducând severitatea focarelor herpetice cu până la 40% în studii clinice
- Propionibacterium acnes — bacteria acneei este inhibată direct de acidul lauric aplicat topic, reducând inflamația și leziunile acneice în 4-8 săptămâni de tratament
Un studiu din 2013 publicat în BioMed Research International arată că uleiul de cocos modificat enzimatic obține 90% inhibare a Staphylococcus aureus și 80% pentru E. coli. Aceste rezultate susțin utilizarea sa ca agent antimicrobian natural în industria alimentară și cosmetică.
5. Susține funcția cognitivă și sănătatea creierului
Cetonele produse din MCT-urile nucii de cocos oferă energie alternativă pentru creier. Când glucoza scade, neuronii folosesc cetone ca sursă de combustibil. Acest mecanism are potențial terapeutic în bolile neurodegenerative precum Alzheimer și Parkinson.
Cercetări preliminare sugerează că MCT-urile îmbunătățesc funcția cognitivă la pacienții cu Alzheimer ușor până la moderat. Creșterea cetonelor serice corelează cu performanță îmbunătățită la testele de memorie și atenție. Un studiu de 6 luni pe 40 de participanți arată că suplimentarea zilnică cu 40ml ulei MCT din cocos îmbunătățește scorurile la Mini-Mental State Examination (MMSE) cu 2,4 puncte față de grupul placebo.
6. Efect asupra greutății corporale și metabolismului
Deși calorică (354 kcal/100g), nuca de cocos poate susține controlul greutății prin mecanisme specifice. MCT-urile cresc termogeneza cu 5-8% comparativ cu grăsimile cu lanț lung. Asta înseamnă mai multe calorii arse în repaus.
O meta-analiză din 2015 în Journal of the Academy of Nutrition and Dietetics evaluează 13 studii clinice. Consumul zilnic de 15-30g MCT reduce greutatea corporală cu 0,5kg în medie după 3 luni, comparativ cu uleiuri vegetale standard. Nu e dramatic, dar e consistent.
Mecanismele includ sațietate crescută (MCT-urile stimulează hormoni anorexigeni), oxidare preferențială (ficatul metabolizează MCT-urile imediat pentru energie) și termogeneză adaptivă (producția de căldură consumă 120-150 calorii extra zilnic).
Efectele sunt moderate și necesită integrare într-o dietă echilibrată. Consumul excesiv de nuca de cocos (peste 50g zilnic) anulează beneficiile prin aportul caloric ridicat.
7. Beneficii pentru piele, păr și unghii
Uleiul de cocos penetrează firul de păr mai eficient decât alte uleiuri vegetale. Structura sa moleculară permite trecerea prin cuticula părului, reducând pierderea de proteine după spălare cu 30-40%. Aplicarea pre-șampon (20-30 minute) protejează keratina și îmbunătățește hidratarea.
Pentru piele, acidul lauric combate bacteria Propionibacterium acnes responsabilă de acnee. Aplicarea topică reduce inflamația și leziunile acneice în 4-8 săptămâni conform studiilor clinice. Vitamina E și compușii fenolici din uleiul de cocos virgin oferă protecție antioxidantă. Neutralizează radicalii liberi cauzați de expunerea UV, încetinind fotoîmbătrânirea.
Produse derivate din nuca de cocos și utilizările lor

Ulei de cocos virgin vs rafinat
Uleiul virgin se extrage la rece din pulpa proaspătă, păstrând toți compușii bioactivi. Are aromă intensă de cocos și conține polifenoli antioxidanți. Se topește la 24°C și este solid la temperatura camerei. Proces minim de prelucrare.
Uleiul rafinat trece prin procese de dezodorizare și albire. Pierde o parte din antioxidanți dar devine neutru la gust și miros. Punctul de fum crește la 232°C, făcându-l mai potrivit pentru gătit la temperaturi înalte.
Pentru beneficii maxime de sănătate, alege ulei de cocos virgin presat la rece. Are concentrație mai mare de acid lauric (49% vs 45%) și păstrează toți compușii fenolici volatili. Certificarea bio garantează absența pesticidelor și solvențiilor chimici.
Lapte și smântână de cocos
Laptele de cocos se obține prin amestecarea pulpei răzuite cu apă caldă și strecurare. Conține 15-20% grăsime și se folosește în curry, smoothie-uri și deserturi. Textura cremoasă și gustul ușor dulce îl fac versatil în bucătărie.
Smântâna de cocos (crema) are concentrație mai mare de grăsimi (25-30%). Se formează natural când laptele de cocos stă la rece peste noapte. Stratul superior solid se separă și poate fi bătut ca smântână pentru cafea sau deserturi.
Ambele produse sunt alternative vegetale excelente pentru persoanele cu intoleranță la lactoză sau care urmează o dietă vegană. Zero proteine lactate, zero colesterol animal.
Făină și zahăr de cocos
Făina de cocos provine din pulpa uscată și măcinată după extragerea uleiului. Conține 58% fibre, 20% proteine și doar 16% carbohidrați. Nu conține gluten, făcând-o potrivită pentru celiacici și persoane cu sensibilitate la gluten.
Absorbția lichidelor este de 2,5 ori mai mare decât făina de grâu. În rețete, folosește doar 25-30% din cantitatea de făină normală și crește lichidele proporțional. Altfel obții o pastă uscată imposibil de lucrat.
Zahărul de cocos se extrage din seva inflorescenței palmierului. Are indice glicemic 35, semnificativ mai scăzut decât zahărul alb (IG 65). Conține inulină, o fibră prebiotică care încetinește absorbția glucozei și hrănește bacteriile benefice intestinale.
Cum să alegi și să păstrezi nuca de cocos
La achiziție, agită nuca lângă ureche. Trebuie să auzi clar lichidul mișcându-se interior. Lipsa sunetului indică deshidratare sau mucegai intern. Test simplu dar eficient.
Verifică cele trei “ochi” de la bază. Nu trebuie să aibă mucegai sau scurgeri. Coaja să fie uniformă, fără crăpături sau pete întunecate care semnalează deteriorare. Greutatea e important indiciu de prospeție.
Nucile tinere (verzi) au pulpă moale, gelatinoasă și apă mai mult. Conțin mai puține grăsimi saturate (18g/100g vs 30g) dar mai multe electroliți. Cele mature (brune) au pulpă albă, tare și concentrație maximă de acizi grași benefici.
Păstrare corectă pentru durata maximă:
- Nucă întreagă nedeschisă — 2-3 luni la temperatura camerei în loc uscat și răcoros, departe de surse de căldură directă sau umiditate excesivă
- Pulpă proaspătă în recipient ermetic — 5-7 zile la frigider (4°C), departe de alimente cu miros puternic care pot fi absorbite rapid
- Pulpă congelată în pungi cu vid — până la 6 luni la -18°C, porționată pentru uz ușor fără decongelări repetate
- Cocos răzuit uscat în borcan de sticlă — 6-12 luni la loc întunecos și uscat, verificat lunar pentru semne de râncezire sau insecte
Cum să deschizi o nucă de cocos în 5 pași simpli
- Găsește “ochiul” moale — Dintre cele trei pete circulare de la bază, unul este mai moale și cedează ușor la apăsare cu degetul mare. Testează fiecare până identifici cel care cedează cel mai ușor.
- Perforează ochiul — Folosește un șurubelniță curățată cu alcool sau un cui dezinfectat pentru a preveni contaminarea. Lovește cu un ciocan până străpungi coaja, creând o gaură de 5-8mm diametru prin mișcări ferme dar controlate.
- Scurge apa de cocos — Întoarce nuca cu gaura în jos deasupra unui pahar curat. Lasă 2-3 minute până se golește complet, mișcând ușor nuca pentru fluidizare. Apa poate fi consumată imediat sau păstrată la frigider maximum 48 ore.
- Sparge coaja — Ține nuca în mână și lovește cu un ciocan pe “ecuatorul” natural (linia care împarte nuca în jumătate). Rotește nuca după fiecare lovitură, făcând tur complet. După 6-8 lovituri strategice, coaja se va crăpa clar de-a lungul liniei.
- Extrage pulpa — Introdu vârful unui cuțit între pulpă și coajă, apoi răsucește ușor pentru a separa fără a forța. Pentru bucăți mari intacte, încălzește nuca 10 minute la 180°C înainte de spargere, pulpa se desprinde semnificativ mai ușor.
Sfat profesionist din experiență: Dacă nuca nu se sparge după prima tură de lovituri, continuă rotind și lovind până auzi un sunet caracteristic de fisură. Nu forța separarea prematur, riscă să spargi nuca în bucăți neregulate și să pierzi din pulpă.
Contraindicații și precauții
Deși nuca de cocos aduce multe beneficii, anumite persoane trebuie să fie precaute sau să evite consumul. Realitatea e mai nuanțată decât pare la prima vedere.
Alergii rare dar posibile — Alergia la nuca de cocos afectează sub 0,5% din populație conform datelor Healthline. Simptomele includ urticarie, umflarea buzelor și dificultăți de respirație. Reacțiile severe (anafilaxie) sunt extrem de rare dar necesită tratament medical urgent cu epinefrină.
Densitate calorică ridicată — 100g pulpă echivalează cu 354 calorii, aproape o masă completă pentru unele persoane. Consumul zilnic peste 50g poate sabota eforturile de scădere în greutate prin surplus caloric neobservat. Măsoară porțiile cu grijă.
Interacțiune cu medicamente — Uleiul de cocos poate crește absorbția unor medicamente liposolubile, modificând dozajul efectiv. Consultă medicul dacă iei anticoagulante (warfarin), antidiabetice (metformin) sau medicamente pentru tiroidă (levotiroxină) înainte de a consuma cantități mari zilnic.
Probleme digestive temporare — Introducerea bruscă a cantităților mari de fibră (9g/100g) poate cauza balonare și crampe abdominale. Începe cu 20-30g zilnic și crește gradual pe parcursul a 2 săptămâni pentru adaptare intestinală progresivă.
Afecțiuni hepatice — Persoanele cu ciroză sau insuficiență hepatică trebuie să limiteze MCT-urile. Ficatul deteriorat poate avea dificultăți în metabolizarea rapidă a acestor acizi grași, crescând sarcina metabolică și riscând decompensarea funcției hepatice.
Comparație: Nuca de cocos vs alte nuci și semințe
| Nutrient (per 100g) | Nuca de cocos | Migdale | Nuci | Caju |
|---|---|---|---|---|
| Calorii | 354 | 579 | 654 | 553 |
| Proteine (g) | 3,3 | 21,2 | 15,2 | 18,2 |
| Grăsimi (g) | 33,5 | 49,9 | 65,2 | 43,8 |
| — Saturate (g) | 29,7 | 3,8 | 6,1 | 7,8 |
| — Mononesaturate (g) | 1,4 | 31,5 | 8,9 | 23,8 |
| Carbohidrați (g) | 15,2 | 21,5 | 13,7 | 30,2 |
| Fibre (g) | 9 | 12,5 | 6,7 | 3,3 |
| Magneziu (mg) | 32 | 270 | 158 | 292 |
| Vitamina E (mg) | 0,24 | 25,6 | 0,7 | 0,9 |
| Indice glicemic | 45 | 15 | 25 | |
| Avantaj principal | MCT + antimicrobian | Vitamina E + fibre | Omega-3 (ALA) | Magneziu + fier |
Concluzie practică: Nuca de cocos este unică prin concentrația extremă de grăsimi saturate cu lanț mediu și proprietățile antimicrobiene. Pentru aport proteic și magneziu, migdalele și caju sunt superioare. Pentru omega-3, nucile câștigă clar. Rotația în dietă oferă beneficii complementare.
Întrebări frecvente despre nuca de cocos
Este nuca de cocos bună pentru persoanele cu diabet zaharat?
Da, nuca de cocos este potrivită pentru diabetici datorită indicelui glicemic scăzut (45) și conținutului mare de fibre (9g/100g) care încetinesc absorbția glucozei în sânge. Studii clinice arată că apa de cocos îmbunătățește sensibilitatea la insulină la modelele animale, iar MCT-urile nu produc spikeuri glicemice bruște. Cu toate acestea, porțiile trebuie limitate la 30-40g zilnic din cauza densității calorice care poate afecta controlul greutății. Integrează nuca de cocos într-un plan alimentar echilibrat pentru diabetici, monitorizând constant glicemia înainte și după consum. Consultă medicul sau nutriționistul pentru ajustarea insulinei dacă modifici semnificativ aportul de grăsimi zilnic.
Câtă nucă de cocos pot consuma zilnic fără să mă îngraș?
Porția optimă recomandată de nutriționiști este 30-40 grame pulpă (aproximativ 3 linguri răzuite sau 8-10 cubulețe mici), aducând 106-141 calorii și 10-13g grăsimi sănătoase cu lanț mediu. Această cantitate oferă beneficiile MCT-urilor pentru metabolism și sațietate fără surplus caloric semnificativ care să contribuie la creștere în greutate. Pentru scădere în greutate activă, limitează la 20-25g zilnic (70-90 calorii) și ajustează restul grăsimilor din dietă proporțional. Dacă folosești ulei de cocos pentru gătit, ia în calcul că o lingură echivalează cu 120 calorii și ajustează porția de pulpă corespunzător pentru a rămâne în cadrul necesarului caloric. Echilibrează grăsimile saturate din cocos cu surse nesaturate precum avocado, nuci și ulei de măsline pentru raport optim și sănătate cardiovasculară pe termen lung.
Uleiul de cocos este mai sănătos decât uleiul de măsline?
Ambele au beneficii distincte și complementare pentru sănătate, fără un câștigător clar absolut. Uleiul de măsline extravirgin conține 73% grăsimi mononesaturate și polifenoli cardioprotectori puternici, fiind recomandat unanim de cardiologi pentru reducerea inflamației și protecția cardiovasculară dovedită în dieta mediteraneană. Uleiul de cocos oferă 62% MCT cu proprietăți antimicrobiene validate științific și potențial cetogenic pentru energie cerebrală, dar conține 82% grăsimi saturate total care pot crește LDL-colesterolul la persoane sensibile. Cercetările recente din Journal of Cardiovascular Diseases arată că grăsimile saturate cu lanț mediu nu afectează inima la fel ca cele cu lanț lung din carne roșie sau unt. Recomandare practică: folosește ulei de măsline pentru salate și preparate crude (beneficii maxime ale antioxidanților), ulei de cocos virgin pentru gătit la foc mare (punct de fum 177°C vs 160°C măsline extravirgin) și alterează ambele pentru diversitate nutritivă și acoperire completă a nevoilor metabolice.
Pot folosi uleiul de cocos pe piele și păr zilnic?
Da, uleiul de cocos virgin este sigur pentru uz zilnic topic pe majoritatea tipurilor de piele și păr, cu rezultate vizibile în 2-4 săptămâni de aplicare constantă. Pentru păr, aplicarea pre-șampon timp de 20-30 minute reduce pierderea de proteine cu 30-40% și îmbunătățește hidratarea profundă a firului, fiind deosebit de eficient pentru păr uscat, deteriorat chimic sau expus frecvent la căldură. Pentru piele corporală, funcționează excelent ca hidratant natural după duș când pielea e încă umedă, dar poate înfunda porii faciali la persoanele cu ten acneic predispus (comedogenic rating 4/5 pe scala 0-5). Testează obligatoriu pe o zonă mică (antebraț sau după ureche) timp de 48 ore înainte de aplicare pe față pentru a detecta reacții alergice sau iritații. Pentru beneficii maxime sinergice pentru păr și piele, combină uleiul de cocos topic cu suplimente orale de biotină 10.000mcg, colagen hidrolizat tip I și III și acid hialuronic pentru rezultate vizibile accelerate. Evită strict contactul cu ochii și membranele mucoase unde poate provoca iritație intensă și necesită clătire abundentă cu apă călduță.
Este apa de cocos mai bună decât băuturile sportive comerciale?
Apa de cocos conține electroliți naturali bioactivi (250mg potasiu, 25mg sodiu, 60mg magneziu per 100ml) și rehidratează la nivel similar cu băuturile sportive comerciale în studii clinice pe eforturi fizice moderate de 60-90 minute. Are avantaje clare: mai puține calorii (19 vs 50-80 kcal/100ml), zahăr natural mai puțin (5g zaharoză vs 14g zahăr rafinat) și zero aditivi artificiali sau coloranți care pot irita sistemul digestiv. Însă conținutul scăzut de sodiu (25mg vs 110mg în Gatorade) o face mai puțin eficientă pentru eforturi intense prelungite peste 90 minute când pierderile de sodiu prin transpirație sunt masive (800-1500mg/oră la atleți de performanță). Cercetările publicate în JISSN arată performanță echivalentă la exerciții moderate cu intensitate 60-75% VO2max și durată sub 90 minute. Concluzie practică: excelentă pentru alergări ușoare, ciclism recreational, antrenamente fitness standard sub 90 minute, dar inferioară pentru maratoane, ultramaratoane, triatlon Ironman sau competiții de anduranță extremă unde necesarul de sodiu depășește capacitatea apei de cocos de a compensa pierderile.
Nuca de cocos crește colesterolul rău (LDL)?
Răspunsul este nuanțat și depinde de factori individuali precum genetică, cantitatea consumată și starea metabolică de bază. Studiile clinice arată rezultate mixte: unele indică creștere ușoară a LDL-colesterolului cu 5-10% la consumuri mari peste 50g zilnic, altele nu raportează modificări semnificative statistic la doze moderate de 30-40g zilnic. Elementul pozitiv este că nuca de cocos crește consistent și HDL-ul (colesterolul bun) cu 15-20% în studii randomizate pe 8-12 săptămâni, îmbunătățind semnificativ raportul total colesterol/HDL care este cel mai puternic predictor cardiovascular pentru risc de infarct și accident vascular. O meta-analiză din 2016 în Nutrition Reviews concluzionează că MCT-urile din cocos nu cresc riscul cardiovascular la persoane sănătoase fără factori de risc preexistenți. Dacă ai hipercolesterolemie familială (LDL genetic ridicat), hipertrigliceridemie sau LDL peste 160mg/dL deja la baseline, consultă obligatoriu cardiologul înainte de consum regulat zilnic pentru monitorizare lipidogramă la 3 luni. Pentru populații insulare din Pacific (Tokelau, Pukapuka, Kitava) unde cocosul reprezintă 30-60% din aportul caloric zilnic, paradoxal ratele bolilor cardiovasculare și infarctelor sunt semnificativ mai scăzute decât în țările occidentale, sugerând că alți factori alimentari și stilul de viață (activitate fizică ridicată, dietă bogată în pește și legume) joacă rol protector major.
Cum afectează nuca de cocos funcția tiroidei?
Există un mit persistent promovat neștiințific că uleiul de cocos “vindecă” sau “reactivează” hipotiroidismul automat, dar realitatea științifică este diferită și mai nuanțată. Nu există dovezi clinice solide randomizate pe oameni că MCT-urile îmbunătățesc direct producția hormonilor tiroidieni TSH, T3 sau T4 la pacienți diagnosticați cu hipotiroidism primar sau Hashimoto. Totuși, cocosul poate ajuta indirect sistemul endocrin prin multiple mecanisme complementare: (1) reducerea inflamației cronice sistemice care afectează negativ conversia T4 în T3 activă la nivel celular periferic, (2) susținerea sănătății intestinale și integrității barierei intestinale care este absolut esențială pentru absorbția optimă a seleniului și zincului necesare enzimelor deiodinaze tiroidiene, (3) stabilizarea glicemiei postprandiale care previne spikeurile de cortizol ce perturbă axa hipotalar-pituitară-tiroidiană și suprimă TSH-ul. MCT-urile nu înlocuiesc NICIODATĂ levotiroxina (Euthyrox), liothyronina sau alte medicamente tiroidiene prescrise medical și NU trebuie redus dozajul fără aprobare endocrinolog. Dacă ai Hashimoto tiroidită autoimună sau Graves hipertiroidism, cercetările sugerează că cocosul poate fi integrat safe ca parte a unui regim alimentar anti-inflamator paleo sau autoimun protocol (AIP), dar nu ca tratament singular izolat care să remedieze cauza autoimună de bază.
Este sigură nuca de cocos pentru copii și sugari?
Nuca de cocos poate fi introdusă în mod sigur în diversificare după vârsta de 6 luni împliniți, similar cu protocoalele internaționale pentru alte nuci, semințe și alergeni alimentari potențiali care se introduc gradual pentru expunere timpurie. Începe cu cantități foarte mici (1/2 linguriță pulpă răzuită fin) mixată omogen în pireu de legume, fructe sau iaurt natural pentru bebeluși, pentru a testa toleranța digestivă și a monitoriza atent eventuale reacții alergice cutanate sau respiratorii în următoarele 48-72 ore. Riscul de asfixiere aspirație este moderat cu bucăți mari neadecvate vârstei, deci răzuiește ÎNTOTDEAUNA fin pulpa sau folosește lapte de cocos natural diluat 1:1 cu apă pentru siguranță maximă la sugari sub 12 luni. Apa de cocos naturală 100% fără zahăr adăugat, conservanți sau aromatizanți artificiali este sigură după 6 luni, oferind 50-100ml zilnic pentru hidratare suplimentară în zilele călduroase sau după febră cu deshidratare ușoară. Evită STRICT produsele comerciale îndulcite artificial sau cu sirop de glucoză-fructoză adăugat care cresc exponențial riscul de carii dentare timpurii și dependență de gust dulce exagerat. Iaurtul de cocos probiotic nesărat este alternativă nutritivă excelentă la iaurturile lactate pentru sugarii diagnosticați cu intoleranță la lactoză congenitală sau alergie la proteinele laptelui de vacă (APLV). Consultă pediatrul specialist înainte de introducere dacă există istoric familial direct de alergii severe la nuci de copacel (migdale, alune, caju) pentru a evalua necesitatea testării alergologice preventive prin prick test sau IgE specific serice.
Surse Bibliografice
OrganicsFood.ro folosește doar surse de încredere, inclusiv studii peer-reviewed și instituții medicale recunoscute internațional, pentru a susține informațiile din articolele noastre despre sănătate și nutriție. Citește mai multe despre procesul nostru editorial și cum verificăm faptele pentru a menține conținutul precis și de încredere.
- National Center for Biotechnology Information. Coconuts and Health: Different Chain Lengths of Saturated Fats Require Different Consideration. Journal of Cardiovascular Diseases, 2020.
- WebMD LLC. Coconut: Health Benefits and Nutrition. Diet & Weight Management, 2024.
- Healthline Media. 5 Health and Nutrition Benefits of Coconut. Nutrition Reviews, 2024.
- U.S. Department of Agriculture. Coconut meat, raw – FoodData Central. Agricultural Research Service, 2024.
- Kalman DS, et al. Comparison of coconut water and a carbohydrate-electrolyte sport drink on measures of hydration and physical performance. Journal of the International Society of Sports Nutrition, 2012.
- Mumme K, Stonehouse W. Effects of medium-chain triglycerides on weight loss and body composition. Journal of the Academy of Nutrition and Dietetics, 2015.
- Nitbani FO, et al. Antimicrobial Properties of Lauric Acid and Monolaurin in Virgin Coconut Oil. ChemBioEng Reviews, Wiley Online Library, 2022.
- Dayrit CS, et al. Lauric Acid Is an Inhibitor of Clostridium difficile Growth in Vitro and Reduces Inflammation. Frontiers in Microbiology, 2017.
- Eyres L, et al. Coconut oil consumption and cardiovascular risk factors in humans. Nutrition Reviews, PMC, 2016.
- Ashton OBO, et al. The Effects of Medium-Chain Triglyceride Oil Supplementation on Endurance Performance. PMC, 2022.
- Famurewa AC, et al. Improvement of Medium Chain Fatty Acid Content and Antimicrobial Activity of Coconut Oil. BioMed Research International, 2013.
- ResearchGate. Coconut: Nutritional and Industrial Significance. Scientific Publication, 2024.
Integrează inteligent nuca de cocos în alimentația ta

Nuca de cocos oferă beneficii reale validate științific prin cercetări clinice riguroase. Acizii grași cu lanț mediu susțin metabolismul eficient și oferă energie rapidă fără depozitare adipoasă excesivă. Proprietățile antimicrobiene ale acidului lauric protejează împotriva bacteriilor patogene și virușilor comuni. Fibrele abundente ajută digestia optimă și controlul glicemiei stabile.
Consumă-o cu moderație practică. 30-40g pulpă zilnic sau 1-2 linguri ulei de cocos virgin sunt suficiente pentru majoritatea oamenilor adulți sănătoși. Variază sursele de grăsimi sănătoase în dieta ta. Alternează strategiс cu avocado bogat în potasiu, nuci cu omega-3 și ulei de măsline extravirgin pentru profil lipidic echilibrat complet.
Nu este aliment miraculos universal. Funcționează optim integrat într-o dietă diversificată, bogată în legume proaspete colorate, fructe de sezon și proteine de calitate superioară din surse variate. Consultă medicul specialist dacă ai afecțiuni cronice cardiovasculare, hepatice sau metabolice sau iei medicamente prescrise înainte de a face modificări majore alimentare.
Începe astăzi cu pași simpli. Adaugă o lingură de cocos răzuit în smoothie dimineață sau folosește ulei de cocos virgin pentru gătit la foc mediu. Efectele pe termen lung depind direct de consistență zilnică și echilibru alimentar general sustenabil.
Disclaimer Legal
Articolele din acest site au exclusiv rol informativ educațional și nu constituie sfaturi medicale profesionale. Administratorii site-ului nu sunt responsabili pentru încercarea de a aplica independent o rețetă, un sfat nutrițional sau o dietă și nici nu garantează că informațiile furnizate vă vor ajuta sau nu vă vor dăuna starea de sănătate personală. Fiți prudenți și responsabili, consultați întotdeauna un medic specialist autorizat sau un nutriționist diplomat înainte de modificări semnificative alimentare!
Vă mulțumim sincer că ați citit acest articol comprehensiv! Dacă acest material vi se pare util, relevant și interesant pentru sănătatea voastră, vă rugăm să îl distribuiți pe rețelele de socializare (Facebook, Instagram, WhatsApp) pentru a fi descoperit și citit de prieteni, familie și cunoștințe. În acest fel ne ajutați direct și ne motivați să scriem mai multe articole informative bazate pe cercetări științifice actuale.

















